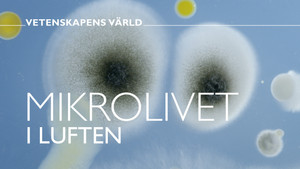
Episode 15

Vetenskapens värld
Vetenskapens värld is a popular science TV documentary program broadcast on Swedish Television (SVT).
Seasons
1. Episode 1
Air Date: 1971-09-26
2. Episode 2
Air Date: 1971-11-21
1. Episode 1
Air Date: 1972-04-16
1. Episode 1
Air Date: 1977-03-20
1. Episode 1
Air Date: 1978-12-18
2. Episode 2
Air Date: 1978-12-20
1. Episode 1
Air Date: 1979-03-05
2. Episode 2
Air Date: 1979-04-09
3. Episode 3
Air Date: 1979-12-28
4. Episode 4
Air Date: 1979-12-29
1. Episode 1
Air Date: 1980-01-15
2. Episode 2
Air Date: 1980-04-19
3. Episode 3
Air Date: 1980-06-16
4. Episode 4
Air Date: 1980-10-04
5. Episode 5
Air Date: 1980-10-18
6. Episode 6
Air Date: 1980-11-29
7. Episode 7
Air Date: 1980-12-13
1. Episode 1
Air Date: 1981-01-24
2. Episode 2
Air Date: 1981-02-21
3. Episode 3
Air Date: 1981-03-21
4. Episode 4
Air Date: 1981-04-25
5. Episode 5
Air Date: 1981-12-22
1. Episode 1
Air Date: 1982-03-11
2. Episode 2
Air Date: 1982-07-08
3. Episode 3
Air Date: 1982-09-18
4. Episode 4
Air Date: 1982-10-23
1. Episode 1
Air Date: 1983-10-31
1. Episode 1
Air Date: 1986-03-02
2. Episode 2
Air Date: 1986-04-06
3. Episode 3
Air Date: 1986-05-04
4. Episode 4
Air Date: 1986-12-02
1. Episode 1
Air Date: 1989-09-22
2. Episode 2
Air Date: 1989-09-29
3. Episode 3
Air Date: 1989-10-06
4. Episode 4
Air Date: 1989-10-13
5. Episode 5
Air Date: 1989-10-20
6. Episode 6
Air Date: 1989-10-27
7. Episode 7
Air Date: 1989-11-03
8. Episode 8
Air Date: 1989-11-10
9. Episode 9
Air Date: 1989-11-17
10. Episode 10
Air Date: 1989-11-24
11. Episode 11
Air Date: 1989-12-01
12. Episode 12
Air Date: 1989-12-08
1. Episode 1
Air Date: 1990-01-12
2. Episode 2
Air Date: 1990-01-19
3. Episode 3
Air Date: 1990-01-26
4. Episode 4
Air Date: 1990-02-02
5. Episode 5
Air Date: 1990-02-09
6. Episode 6
Air Date: 1990-02-16
7. Episode 7
Air Date: 1990-02-23
8. Episode 8
Air Date: 1990-03-02
9. Episode 9
Air Date: 1990-03-09
10. Episode 10
Air Date: 1990-03-23
11. Episode 11
Air Date: 1990-03-30
12. Episode 12
Air Date: 1990-04-06
13. Episode 13
Air Date: 1990-04-13
14. Episode 14
Air Date: 1990-04-20
15. Episode 15
Air Date: 1990-10-19
16. Episode 16
Air Date: 1990-10-26
17. Episode 17
Air Date: 1990-11-02
18. Episode 18
Air Date: 1990-11-09
19. Episode 19
Air Date: 1990-11-16
20. Episode 20
Air Date: 1990-11-23
21. Episode 21
Air Date: 1990-11-30
22. Episode 22
Air Date: 1990-12-07
23. Episode 23
Air Date: 1990-12-14
24. Episode 24
Air Date: 1990-12-21
1. Episode 1
Air Date: 1991-04-05
2. Episode 2
Air Date: 1991-04-12
3. Episode 3
Air Date: 1991-05-03
4. Episode 4
Air Date: 1991-05-10
5. Episode 5
Air Date: 1991-05-17
6. Episode 6
Air Date: 1991-06-07
7. Episode 7
Air Date: 1991-06-14
8. Episode 8
Air Date: 1991-10-11
9. Episode 9
Air Date: 1991-10-18
10. Episode 10
Air Date: 1991-10-25
11. Episode 11
Air Date: 1991-11-08
12. Episode 12
Air Date: 1991-11-15
13. Episode 13
Air Date: 1991-11-22
14. Episode 14
Air Date: 1991-12-06
1. Episode 1
Air Date: 1992-01-02
2. Episode 2
Air Date: 1992-01-06
3. Episode 3
Air Date: 1992-01-09
4. Episode 4
Air Date: 1992-02-29
5. Episode 5
Air Date: 1992-03-07
6. Episode 6
Air Date: 1992-03-14
7. Episode 7
Air Date: 1992-03-21
8. Episode 8
Air Date: 1992-03-28
9. Episode 9
Air Date: 1992-04-04
10. Episode 10
Air Date: 1992-04-11
11. Episode 11
Air Date: 1992-04-18
12. Episode 12
Air Date: 1992-04-25
13. Episode 13
Air Date: 1992-05-02
14. Episode 14
Air Date: 1992-05-09
15. Episode 15
Air Date: 1992-11-01
16. Episode 16
Air Date: 1992-11-08
17. Episode 17
Air Date: 1992-11-15
18. Episode 18
Air Date: 1992-11-22
19. Episode 19
Air Date: 1992-11-29
20. Episode 20
Air Date: 1992-12-06
21. Episode 21
Air Date: 1992-12-13
22. Episode 22
Air Date: 1992-12-20
1. Episode 1
Air Date: 1993-02-28
2. Episode 2
Air Date: 1993-03-14
3. Episode 3
Air Date: 1993-03-28
4. Episode 4
Air Date: 1993-04-11
5. Episode 5
Air Date: 1993-04-25
6. Episode 6
Air Date: 1993-05-09
7. Episode 7
Air Date: 1993-05-16
8. Episode 8
Air Date: 1993-05-23
9. Episode 9
Air Date: 1993-06-06
10. Episode 10
Air Date: 1993-09-12
11. Episode 11
Air Date: 1993-09-26
12. Episode 12
Air Date: 1993-10-10
13. Episode 13
Air Date: 1993-10-24
14. Episode 14
Air Date: 1993-11-07
15. Episode 15
Air Date: 1993-11-14
16. Episode 16
Air Date: 1993-11-21
17. Episode 17
Air Date: 1993-11-28
18. Episode 18
Air Date: 1993-12-12
1. Episode 1
Air Date: 1994-02-27
2. Episode 2
Air Date: 1994-03-13
3. Episode 3
Air Date: 1994-03-27
4. Episode 4
Air Date: 1994-04-10
5. Episode 5
Air Date: 1994-04-24
6. Episode 6
Air Date: 1994-05-08
7. Episode 7
Air Date: 1994-05-22
8. Episode 8
Air Date: 1994-06-05
9. Episode 9
Air Date: 1994-09-11
10. Episode 10
Air Date: 1994-09-25
11. Episode 11
Air Date: 1994-10-09
12. Episode 12
Air Date: 1994-11-20
13. Episode 13
Air Date: 1994-12-04
14. Episode 14
Air Date: 1994-12-11
1. Episode 1
Air Date: 1995-01-15
2. Episode 2
Air Date: 1995-01-29
3. Episode 3
Air Date: 1995-02-12
4. Episode 4
Air Date: 1995-02-26
5. Episode 5
Air Date: 1995-03-12
6. Episode 6
Air Date: 1995-04-30
7. Episode 7
Air Date: 1995-05-14
8. Episode 8
Air Date: 1995-05-28
9. Episode 9
Air Date: 1995-06-11
10. Episode 10
Air Date: 1995-06-25
11. Episode 11
Air Date: 1995-10-01
12. Episode 12
Air Date: 1995-10-15
13. Episode 13
Air Date: 1995-11-12
14. Episode 14
Air Date: 1995-12-17
15. Episode 15
Air Date: 1995-12-27
1. Episode 1
Air Date: 1996-01-01
2. Episode 2
Air Date: 1996-01-03
3. Episode 3
Air Date: 1996-01-04
4. Episode 4
Air Date: 1996-01-21
5. Episode 5
Air Date: 1996-02-04
6. Episode 6
Air Date: 1996-02-18
7. Episode 7
Air Date: 1996-03-03
8. Episode 8
Air Date: 1996-03-17
9. Episode 9
Air Date: 1996-03-31
10. Episode 10
Air Date: 1996-04-14
11. Episode 11
Air Date: 1996-05-12
12. Episode 12
Air Date: 1996-06-16
13. Episode 13
Air Date: 1996-07-21
14. Episode 14
Air Date: 1996-08-04
15. Episode 15
Air Date: 1996-08-18
16. Episode 16
Air Date: 1996-09-02
17. Episode 17
Air Date: 1996-09-16
18. Episode 18
Air Date: 1996-10-14
19. Episode 19
Air Date: 1996-10-28
20. Episode 20
Air Date: 1996-11-25
1. Episode 1
Air Date: 1997-01-11
2. Episode 2
Air Date: 1997-01-25
3. Episode 3
Air Date: 1997-02-08
4. Episode 4
Air Date: 1997-02-22
5. Episode 5
Air Date: 1997-03-08
6. Episode 6
Air Date: 1997-03-22
7. Episode 7
Air Date: 1997-04-12
8. Episode 8
Air Date: 1997-04-19
9. Episode 9
Air Date: 1997-05-03
10. Episode 10
Air Date: 1997-05-17
11. Episode 11
Air Date: 1997-05-31
12. Episode 12
Air Date: 1997-06-14
13. Episode 13
Air Date: 1997-06-28
14. Episode 14
Air Date: 1997-09-06
15. Episode 15
Air Date: 1997-09-13
16. Episode 16
Air Date: 1997-09-20
17. Episode 17
Air Date: 1997-09-27
18. Episode 18
Air Date: 1997-11-15
19. Episode 19
Air Date: 1997-11-22
20. Episode 20
Air Date: 1997-11-29
21. Episode 21
Air Date: 1997-12-06
22. Episode 22
Air Date: 1997-12-13
23. Episode 23
Air Date: 1997-12-20
1. Episode 1
Air Date: 1998-01-11
2. Episode 2
Air Date: 1998-01-25
3. Episode 3
Air Date: 1998-02-08
4. Episode 4
Air Date: 1998-02-22
5. Episode 5
Air Date: 1998-03-08
6. Episode 6
Air Date: 1998-03-22
7. Episode 7
Air Date: 1998-04-05
8. Episode 8
Air Date: 1998-04-19
9. Episode 9
Air Date: 1998-05-03
10. Episode 10
Air Date: 1998-05-17
11. Episode 11
Air Date: 1998-05-31
12. Episode 12
Air Date: 1998-11-22
13. Episode 13
Air Date: 1998-11-29
14. Episode 14
Air Date: 1998-12-06
15. Episode 15
Air Date: 1998-12-13
16. Episode 16
Air Date: 1998-12-20
17. Episode 17
Air Date: 1998-12-27
1. Episode 1
Air Date: 1999-01-31
2. Episode 2
Air Date: 1999-02-14
3. Episode 3
Air Date: 1999-02-28
4. Episode 4
Air Date: 1999-03-14
5. Episode 5
Air Date: 1999-03-28
6. Episode 6
Air Date: 1999-04-25
7. Episode 7
Air Date: 1999-05-09
8. Episode 8
Air Date: 1999-05-23
9. Episode 9
Air Date: 1999-06-13
10. Episode 10
Air Date: 1999-06-20
11. Episode 11
Air Date: 1999-09-12
12. Episode 12
Air Date: 1999-09-26
13. Episode 13
Air Date: 1999-10-10
14. Episode 14
Air Date: 1999-10-24
15. Episode 15
Air Date: 1999-11-07
16. Episode 16
Air Date: 1999-11-21
17. Episode 17
Air Date: 1999-12-05
18. Episode 18
Air Date: 1999-12-19
1. Episode 1
Air Date: 2000-01-10
2. Episode 2
Air Date: 2000-01-24
3. Episode 3
Air Date: 2000-02-07
4. Episode 4
Air Date: 2000-02-21
5. Episode 5
Air Date: 2000-03-06
6. Episode 6
Air Date: 2000-03-20
7. Episode 7
Air Date: 2000-04-03
8. Episode 8
Air Date: 2000-04-17
9. Episode 9
Air Date: 2000-05-01
10. Episode 10
Air Date: 2000-05-15
11. Episode 11
Air Date: 2000-09-04
12. Episode 12
Air Date: 2000-09-18
13. Episode 13
Air Date: 2000-10-02
14. Episode 14
Air Date: 2000-10-16
15. Episode 15
Air Date: 2000-10-30
16. Episode 16
Air Date: 2000-11-13
17. Episode 17
Air Date: 2000-11-27
18. Episode 18
Air Date: 2000-12-11
1. Episode 1
Air Date: 2001-02-05
2. Episode 2
Air Date: 2001-02-19
3. Episode 3
Air Date: 2001-03-05
4. Episode 4
Air Date: 2001-03-19
5. Episode 5
Air Date: 2001-04-02
6. Episode 6
Air Date: 2001-04-16
7. Episode 7
Air Date: 2001-04-30
8. Episode 8
Air Date: 2001-05-14
9. Episode 9
Air Date: 2001-05-28
10. Episode 10
Air Date: 2001-06-11
11. Episode 11
Air Date: 2001-08-27
12. Episode 12
Air Date: 2001-09-10
13. Episode 13
Air Date: 2001-09-24
14. Episode 14
Air Date: 2001-10-08
15. Episode 15
Air Date: 2001-10-22
16. Episode 16
Air Date: 2001-11-05
17. Episode 17
Air Date: 2001-11-19
18. Episode 18
Air Date: 2001-12-03
19. Episode 19
Air Date: 2001-12-17
1. Episode 1
Air Date: 2002-01-07
2. Episode 2
Air Date: 2002-01-21
3. Episode 3
Air Date: 2002-02-04
4. Episode 4
Air Date: 2002-03-04
5. Episode 5
Air Date: 2002-03-18
6. Episode 6
Air Date: 2002-04-01
7. Episode 7
Air Date: 2002-04-15
8. Episode 8
Air Date: 2002-04-29
9. Episode 9
Air Date: 2002-05-13
10. Episode 10
Air Date: 2002-05-27
11. Episode 11
Air Date: 2002-08-26
12. Episode 12
Air Date: 2002-09-09
13. Episode 13
Air Date: 2002-09-23
14. Episode 14
Air Date: 2002-10-07
15. Episode 15
Air Date: 2002-10-21
16. Episode 16
Air Date: 2002-11-04
17. Episode 17
Air Date: 2002-11-18
18. Episode 18
Air Date: 2002-12-02
19. Episode 19
Air Date: 2002-12-16
1. Episode 1
Air Date: 2003-01-13
2. Episode 2
Air Date: 2003-01-20
3. Episode 3
Air Date: 2003-01-27
4. Episode 4
Air Date: 2003-02-03
5. Episode 5
Air Date: 2003-02-10
6. Episode 6
Air Date: 2003-02-17
7. Episode 7
Air Date: 2003-02-24
8. Episode 8
Air Date: 2003-03-03
9. Episode 9
Air Date: 2003-03-10
10. Episode 10
Air Date: 2003-08-18
11. Episode 11
Air Date: 2003-08-25
12. Episode 12
Air Date: 2003-09-01
13. Episode 13
Air Date: 2003-09-08
14. Episode 14
Air Date: 2003-09-22
15. Episode 15
Air Date: 2003-09-29
16. Episode 16
Air Date: 2003-10-06
17. Episode 17
Air Date: 2003-10-13
18. Episode 18
Air Date: 2003-10-20
1. Episode 1
Air Date: 2004-01-12
2. Episode 2
Air Date: 2004-01-19
3. Episode 3
Air Date: 2004-01-26
4. Episode 4
Air Date: 2004-02-02
5. Episode 5
Air Date: 2004-02-09
6. Episode 6
Air Date: 2004-02-16
7. Episode 7
Air Date: 2004-02-23
8. Episode 8
Air Date: 2004-03-01
9. Episode 9
Air Date: 2004-03-08
10. Episode 10
Air Date: 2004-08-30
11. Episode 11
Air Date: 2004-09-06
12. Episode 12
Air Date: 2004-09-13
13. Episode 13
Air Date: 2004-09-20
14. Episode 14
Air Date: 2004-09-27
15. Episode 15
Air Date: 2004-10-04
16. Episode 16
Air Date: 2004-10-11
17. Episode 17
Air Date: 2004-10-18
18. Episode 18
Air Date: 2004-10-25
1. Episode 1
Air Date: 2005-01-10
2. Episode 2
Air Date: 2005-01-17
3. Episode 3
Air Date: 2005-01-24
4. Episode 4
Air Date: 2005-01-31
5. Episode 5
Air Date: 2005-02-07
6. Episode 6
Air Date: 2005-02-14
7. Episode 7
Air Date: 2005-02-21
8. Episode 8
Air Date: 2005-02-28
9. Episode 9
Air Date: 2005-03-07
10. Episode 10
Air Date: 2005-03-14
1. Episode 1
Air Date: 2006-01-12
2. Episode 2
Air Date: 2006-01-19
3. Episode 3
Air Date: 2006-01-26
4. Episode 4
Air Date: 2006-02-02
5. Episode 5
Air Date: 2006-02-09
6. Episode 6
Air Date: 2006-03-02
7. Episode 7
Air Date: 2006-03-09
8. Episode 8
Air Date: 2006-03-16
9. Episode 9
Air Date: 2006-09-14
10. Episode 10
Air Date: 2006-09-21
11. Episode 11
Air Date: 2006-09-28
12. Episode 12
Air Date: 2006-10-05
13. Episode 13
Air Date: 2006-10-12
14. Episode 14
Air Date: 2006-10-19
15. Episode 15
Air Date: 2006-10-26
16. Episode 16
Air Date: 2006-11-02
1. Episode 1
Air Date: 2007-01-18
2. Episode 2
Air Date: 2007-01-25
3. Episode 3
Air Date: 2007-02-01
4. Episode 4
Air Date: 2007-02-08
5. Episode 5
Air Date: 2007-02-15
6. Episode 6
Air Date: 2007-02-22
7. Episode 7
Air Date: 2007-03-01
8. Episode 8
Air Date: 2007-03-08
9. Episode 9
Air Date: 2007-03-15
10. Episode 10
Air Date: 2007-03-22
11. Episode 11
Air Date: 2007-08-20
12. Episode 12
Air Date: 2007-08-27
13. Episode 13
Air Date: 2007-09-03
14. Episode 14
Air Date: 2007-09-10
15. Episode 15
Air Date: 2007-09-17
16. Episode 16
Air Date: 2007-10-01
17. Episode 17
Air Date: 2007-10-08
18. Episode 18
Air Date: 2007-10-15
19. Episode 19
Air Date: 2007-10-22
20. Episode 20
Air Date: 2007-10-29
1. Episode 1
Air Date: 2008-01-28
2. Episode 2
Air Date: 2008-02-04
3. Episode 3
Air Date: 2008-02-11
4. Episode 4
Air Date: 2008-02-18
5. Episode 5
Air Date: 2008-02-25
6. Episode 6
Air Date: 2008-03-03
7. Episode 7
Air Date: 2008-03-10
8. Episode 8
Air Date: 2008-03-17
9. Episode 9
Air Date: 2008-03-24
10. Episode 10
Air Date: 2008-03-31
11. Episode 11
Air Date: 2008-08-25
12. Episode 12
Air Date: 2008-09-01
13. Episode 13
Air Date: 2008-09-08
14. Episode 14
Air Date: 2008-09-15
15. Episode 15
Air Date: 2008-09-22
16. Episode 16
Air Date: 2008-09-29
17. Episode 17
Air Date: 2008-10-06
18. Episode 18
Air Date: 2008-10-13
19. Episode 19
Air Date: 2008-10-20
20. Episode 20
Air Date: 2008-10-27
1. Episode 1
Air Date: 2009-04-06
2. Episode 2
Air Date: 2009-04-13
3. Episode 3
Air Date: 2009-04-20
4. Episode 4
Air Date: 2009-04-27
5. Episode 5
Air Date: 2009-05-04
6. Episode 6
Air Date: 2009-05-11
7. Episode 7
Air Date: 2009-05-18
8. Episode 8
Air Date: 2009-05-25
9. Episode 9
Air Date: 2009-11-02
10. Episode 10
Air Date: 2009-11-09
11. Episode 11
Air Date: 2009-11-16
12. Episode 12
Air Date: 2009-11-23
13. Episode 13
Air Date: 2009-11-30
14. Episode 14
Air Date: 2009-12-07
15. Episode 15
Air Date: 2009-12-14
16. Episode 16
Air Date: 2009-12-21
1. Episode 1
Air Date: 2010-01-25
2. Episode 2
Air Date: 2010-02-01
3. Episode 3
Air Date: 2010-02-08
4. Episode 4
Air Date: 2010-02-15
5. Episode 5
Air Date: 2010-02-22
6. Episode 6
Air Date: 2010-03-01
7. Episode 7
Air Date: 2010-03-08
8. Episode 8
Air Date: 2010-03-15
9. Episode 9
Air Date: 2010-03-22
10. Episode 10
Air Date: 2010-03-29
11. Episode 11
Air Date: 2010-04-05
12. Episode 12
Air Date: 2010-04-12
13. Episode 13
Air Date: 2010-04-19
14. Episode 14
Air Date: 2010-04-26
15. Episode 15
Air Date: 2010-05-03
16. Episode 16
Air Date: 2010-05-10
17. Episode 17
Air Date: 2010-05-17
18. Episode 18
Air Date: 2010-05-24
19. Episode 19
Air Date: 2010-08-23
20. Episode 20
Air Date: 2010-08-30
21. Episode 21
Air Date: 2010-09-06
22. Episode 22
Air Date: 2010-09-13
23. Episode 23
Air Date: 2010-09-20
24. Episode 24
Air Date: 2010-09-27
25. Episode 25
Air Date: 2010-10-04
26. Episode 26
Air Date: 2010-10-11
27. Episode 27
Air Date: 2010-10-18
28. Episode 28
Air Date: 2010-10-25
29. Episode 29
Air Date: 2010-11-01
30. Episode 30
Air Date: 2010-11-08
31. Episode 31
Air Date: 2010-11-15
32. Episode 32
Air Date: 2010-11-22
33. Episode 33
Air Date: 2010-11-29
34. Episode 34
Air Date: 2010-12-06
35. Episode 35
Air Date: 2010-12-13
36. Episode 36
Air Date: 2010-12-20
1. Episode 1
Air Date: 2011-01-31
2. Episode 2
Air Date: 2011-02-07
3. Episode 3
Air Date: 2011-02-14
4. Episode 4
Air Date: 2011-02-21
5. Episode 5
Air Date: 2011-02-28
6. Episode 6
Air Date: 2011-03-07
7. Episode 7
Air Date: 2011-03-14
8. Episode 8
Air Date: 2011-03-21
9. Episode 9
Air Date: 2011-03-28
10. Episode 10
Air Date: 2011-04-04
11. Episode 11
Air Date: 2011-04-11
12. Episode 12
Air Date: 2011-04-18
13. Episode 13
Air Date: 2011-04-25
14. Episode 14
Air Date: 2011-05-02
15. Episode 15
Air Date: 2011-05-09
16. Episode 16
Air Date: 2011-05-16
17. Episode 17
Air Date: 2011-05-23
18. Episode 18
Air Date: 2011-08-22
19. Episode 19
Air Date: 2011-08-29
20. Episode 20
Air Date: 2011-09-05
21. Episode 21
Air Date: 2011-09-12
22. Episode 22
Air Date: 2011-09-12
23. Episode 23
Air Date: 2011-09-19
24. Episode 24
Air Date: 2011-09-26
25. Episode 25
Air Date: 2011-10-03
26. Episode 26
Air Date: 2011-10-10
27. Episode 27
Air Date: 2011-10-17
28. Episode 28
Air Date: 2011-10-24
29. Episode 29
Air Date: 2011-10-31
30. Episode 30
Air Date: 2011-11-07
31. Episode 31
Air Date: 2011-11-14
32. Episode 32
Air Date: 2011-11-21
33. Episode 33
Air Date: 2011-11-28
34. Episode 34
Air Date: 2011-12-05
35. Episode 35
Air Date: 2011-12-12
36. Episode 36
Air Date: 2011-12-19
1. Episode 1
Air Date: 2012-01-30
2. Episode 2
Air Date: 2012-02-06
3. Episode 3
Air Date: 2012-02-13
4. Episode 4
Air Date: 2012-02-20
5. Episode 5
Air Date: 2012-02-27
6. Episode 6
Air Date: 2012-03-05
7. Episode 7
Air Date: 2012-03-12
8. Episode 8
Air Date: 2012-03-19
9. Episode 9
Air Date: 2012-03-26
10. Episode 10
Air Date: 2012-04-02
11. Episode 11
Air Date: 2012-04-09
12. Episode 12
Air Date: 2012-04-16
13. Episode 13
Air Date: 2012-04-23
14. Episode 14
Air Date: 2012-04-30
15. Episode 15
Air Date: 2012-05-07
16. Episode 16
Air Date: 2012-05-14
17. Episode 17
Air Date: 2012-05-21
18. Episode 18
Air Date: 2012-05-28
19. Episode 19
Air Date: 2012-08-20
20. Episode 20
Air Date: 2012-08-27
21. Episode 21
Air Date: 2012-09-03
22. Episode 22
Air Date: 2012-09-10
23. Episode 23
Air Date: 2012-09-17
24. Episode 24
Air Date: 2012-09-24
25. Episode 25
Air Date: 2012-10-01
26. Episode 26
Air Date: 2012-10-08
27. Episode 27
Air Date: 2012-10-15
28. Episode 28
Air Date: 2012-10-22
29. Episode 29
Air Date: 2012-10-29
30. Episode 30
Air Date: 2012-11-05
31. Episode 31
Air Date: 2012-11-12
32. Episode 32
Air Date: 2012-11-19
33. Episode 33
Air Date: 2012-12-03
34. Episode 34
Air Date: 2012-12-17
1. Episode 1
Air Date: 2013-01-14
2. Episode 2
Air Date: 2013-01-21
3. Episode 3
Air Date: 2013-01-28
4. Episode 4
Air Date: 2013-02-04
5. Episode 5
Air Date: 2013-02-11
6. Episode 6
Air Date: 2013-02-18
7. Episode 7
Air Date: 2013-02-25
8. Episode 8
Air Date: 2013-03-04
9. Episode 9
Air Date: 2013-03-11
10. Episode 10
Air Date: 2013-03-18
11. Episode 11
Air Date: 2013-03-25
12. Episode 12
Air Date: 2013-04-01
13. Episode 13
Air Date: 2013-04-08
14. Episode 14
Air Date: 2013-04-15
15. Episode 15
Air Date: 2013-04-22
16. Episode 16
Air Date: 2013-04-29
17. Episode 17
Air Date: 2013-05-06
18. Episode 18
Air Date: 2013-05-13
19. Episode 19
Air Date: 2013-08-26
20. Episode 20
Air Date: 2013-09-02
21. Episode 21
Air Date: 2013-09-09
22. Episode 22
Air Date: 2013-09-16
23. Episode 23
Air Date: 2013-09-23
24. Episode 24
Air Date: 2013-09-30
25. Episode 25
Air Date: 2013-10-07
26. Episode 26
Air Date: 2013-10-14
27. Episode 27
Air Date: 2013-10-21
28. Episode 28
Air Date: 2013-10-28
29. Episode 29
Air Date: 2013-11-04
30. Episode 30
Air Date: 2013-11-11
31. Episode 31
Air Date: 2013-11-18
32. Episode 32
Air Date: 2013-11-25
33. Episode 33
Air Date: 2013-12-02
34. Episode 34
Air Date: 2013-12-09
35. Episode 35
Air Date: 2013-12-16
36. Episode 36
Air Date: 2013-12-23
1. Episode 1
Air Date: 2014-01-20
2. Episode 2
Air Date: 2014-01-27
3. Episode 3
Air Date: 2014-02-03
4. Episode 4
Air Date: 2014-02-10
5. Episode 5
Air Date: 2014-02-17
6. Episode 6
Air Date: 2014-02-24
7. Episode 7
Air Date: 2014-03-03
8. Episode 8
Air Date: 2014-03-10
9. Episode 9
Air Date: 2014-03-17
10. Episode 10
Air Date: 2014-03-24
11. Episode 11
Air Date: 2014-03-31
12. Episode 12
Air Date: 2014-04-07
13. Episode 13
Air Date: 2014-04-14
14. Episode 14
Air Date: 2014-04-21
15. Episode 15
Air Date: 2014-04-28
16. Episode 16
Air Date: 2014-05-12
17. Episode 17
Air Date: 2014-05-19
18. Episode 18
Air Date: 2014-08-18
19. Episode 19
Air Date: 2014-08-25
20. Episode 20
Air Date: 2014-09-08
21. Episode 21
Air Date: 2014-09-22
22. Episode 22
Air Date: 2014-09-29
23. Episode 23
Air Date: 2014-10-06
24. Episode 24
Air Date: 2014-10-13
25. Episode 25
Air Date: 2014-10-20
26. Episode 26
Air Date: 2014-10-27
27. Episode 27
Air Date: 2014-11-03
28. Episode 28
Air Date: 2014-11-10
29. Episode 29
Air Date: 2014-11-17
30. Episode 30
Air Date: 2014-11-24
31. Episode 31
Air Date: 2014-12-01
32. Episode 32
Air Date: 2014-12-08
33. Episode 33
Air Date: 2014-12-15
34. Episode 34
Air Date: 2014-12-22

1. Episode 1
Air Date: 2015-01-19
2. Episode 2
Air Date: 2015-01-26
3. Episode 3
Air Date: 2015-02-02
4. Episode 4
Air Date: 2014-02-09
5. Episode 5
Air Date: 2015-02-16
6. Episode 6
Air Date: 2015-03-02
7. Episode 7
Air Date: 2015-03-09
8. Episode 8
Air Date: 2015-03-16
9. Episode 9
Air Date: 2015-03-23
10. Episode 10
Air Date: 2015-03-30
11. Episode 11
Air Date: 2015-04-06
12. Episode 12
Air Date: 2015-04-13

13. Episode 13
Air Date: 2015-04-20
14. Episode 14
Air Date: 2015-04-27

15. Mass extinction
Air Date: 2015-05-04
At least 5 times all life on earth has been on the verge of extinction. Some say that we are close to the sixth. In this episode the scientists take a closer look at the mass extinctions in our history. What did really happen 250 million years ago, when 95 percent of all sea-living species died out? Is there something we can learn, that we can use today, when the number of species on earth is dwindling and the eco systems are quickly changing?

16. Episode 16
Air Date: 2015-05-11

17. Episode 17
Air Date: 2015-05-18
18. Episode 18
Air Date: 2015-05-25

19. Mars Makalös
Air Date: 2015-08-24
Mars Peerless - the story about Erik XIV and the biggest warship in the world. It was a sensation in the marine archeology world when the fabled warship Mars Peerless (Makalös) was found at the bottom of the Baltic Sea in the summer of 2011, after nearly 450 years of fruitless searches. Mars was bigger than the Vasa ship and it was Erik´s big trump card to win dominion of the Baltic Sea. During three seasons the archeologists have thoroughly investigated the ship and in this autumn premiere of Vetenskapens värld we tell you about a brutal naval battle with a violent outcome. When Mars sank it took around 800 Swedish and German sailors with it to the bottom of the sea.

20. Episode 20
Air Date: 2015-08-31

21. Episode 21
Air Date: 2015-09-07
22. Episode 22
Air Date: 2015-09-14
23. Episode 23
Air Date: 2015-09-21
24. Episode 24
Air Date: 2015-09-28
25. Episode 25
Air Date: 2015-10-05
26. Episode 26
Air Date: 2015-10-12
27. Episode 27
Air Date: 2015-10-19
28. Episode 28
Air Date: 2015-10-26
29. Episode 29
Air Date: 2015-11-02
30. Episode 30
Air Date: 2015-11-09
31. Episode 31
Air Date: 2015-11-16
32. Episode 32
Air Date: 2015-11-23
33. Episode 33
Air Date: 2015-11-30
34. Episode 34
Air Date: 2015-12-07
35. Episode 35
Air Date: 2015-12-14
36. Episode 36
Air Date: 2015-12-21
1. Episode 1
Air Date: 2016-01-25
2. Episode 2
Air Date: 2016-02-01
3. Episode 3
Air Date: 2016-02-08
4. Episode 4
Air Date: 2016-02-15
5. Episode 5
Air Date: 2016-02-22
6. Episode 6
Air Date: 2016-02-29
7. Episode 7
Air Date: 2016-03-07
8. Episode 8
Air Date: 2016-03-14
9. Episode 9
Air Date: 2016-03-21
10. Episode 10
Air Date: 2016-03-28
11. Episode 11
Air Date: 2016-04-04
12. Episode 12
Air Date: 2016-04-11
13. Episode 13
Air Date: 2016-04-18
14. Episode 14
Air Date: 2016-04-25
15. Episode 15
Air Date: 2016-05-02
16. Episode 16
Air Date: 2016-05-09
17. Episode 17
Air Date: 2016-05-16

18. Episode 18
Air Date: 2016-05-23

19. Episode 19
Air Date: 2016-05-30
20. Episode 20
Air Date: 2016-08-22
21. Episode 21
Air Date: 2016-08-29
22. Episode 22
Air Date: 2016-09-05
23. Episode 23
Air Date: 2016-09-12
24. Episode 24
Air Date: 2016-09-19
25. Episode 25
Air Date: 2016-09-26
26. Episode 26
Air Date: 2016-10-03
27. Episode 27
Air Date: 2016-10-10
28. Episode 28
Air Date: 2016-10-17
29. Episode 29
Air Date: 2016-10-24
30. Episode 30
Air Date: 2016-10-31
31. Episode 31
Air Date: 2016-11-07
32. Episode 32
Air Date: 2016-11-14
33. Episode 33
Air Date: 2016-11-21
34. Episode 34
Air Date: 2016-11-28
35. Episode 35
Air Date: 2016-12-05
36. Episode 36
Air Date: 2016-12-19
1. Episode 1
Air Date: 2017-01-16
2. Episode 2
Air Date: 2017-01-23
3. Episode 3
Air Date: 2017-01-30
4. Episode 4
Air Date: 2017-02-13
5. Episode 5
Air Date: 2017-02-20
6. Episode 6
Air Date: 2017-02-27
7. Episode 7
Air Date: 2017-03-06
8. Episode 8
Air Date: 2017-03-13
9. Episode 9
Air Date: 2017-03-20
10. Episode 10
Air Date: 2017-03-27
11. Episode 11
Air Date: 2017-04-03
12. Episode 12
Air Date: 2017-04-10
13. Episode 13
Air Date: 2017-04-17
14. Episode 14
Air Date: 2017-04-24
15. Episode 15
Air Date: 2017-05-01
16. Episode 16
Air Date: 2017-05-08
17. Episode 17
Air Date: 2017-05-15
18. Episode 18
Air Date: 2017-05-22
19. Episode 19
Air Date: 2017-08-21
20. Episode 20
Air Date: 2017-08-28
21. Episode 21
Air Date: 2017-09-04

22. Episode 22
Air Date: 2017-09-11
23. Episode 23
Air Date: 2017-09-18
24. Episode 24
Air Date: 2017-09-25
25. Episode 25
Air Date: 2017-10-02
26. Episode 26
Air Date: 2017-10-09
27. Episode 27
Air Date: 2017-10-16
28. Episode 28
Air Date: 2017-10-23
29. Episode 29
Air Date: 2017-10-30
30. Episode 30
Air Date: 2017-11-06
31. Episode 31
Air Date: 2017-11-13
32. Episode 32
Air Date: 2017-11-20
33. Episode 33
Air Date: 2017-11-27
34. Episode 34
Air Date: 2017-12-04
35. Episode 35
Air Date: 2017-12-18
1. Episode 1
Air Date: 2018-01-22
2. Episode 2
Air Date: 2018-01-29
3. Episode 3
Air Date: 2018-02-05
4. Episode 4
Air Date: 2018-02-12
5. Episode 5
Air Date: 2018-02-19
6. Episode 6
Air Date: 2018-02-26
7. Episode 7
Air Date: 2018-03-05
8. Episode 8
Air Date: 2018-03-12
9. Episode 9
Air Date: 2018-03-19
10. Episode 10
Air Date: 2018-03-26
11. Episode 11
Air Date: 2018-04-02
12. Episode 12
Air Date: 2018-04-09

13. Episode 13
Air Date: 2018-04-16
14. Episode 14
Air Date: 2018-04-23
15. Episode 15
Air Date: 2018-04-30
16. Episode 16
Air Date: 2018-05-07
17. Episode 17
Air Date: 2018-05-14

18. Episode 18
Air Date: 2018-05-21
19. Episode 19
Air Date: 2018-08-27
20. Episode 20
Air Date: 2018-09-03

21. Episode 21
Air Date: 2018-09-17
22. Episode 22
Air Date: 2018-09-24
23. Episode 23
Air Date: 2018-10-01
24. Episode 24
Air Date: 2018-10-08
25. Episode 25
Air Date: 2018-10-22
26. Episode 26
Air Date: 2018-10-29
27. Episode 27
Air Date: 2018-11-05
28. Episode 28
Air Date: 2018-11-12
29. Episode 29
Air Date: 2018-11-19
30. Episode 30
Air Date: 2018-11-26
31. Episode 31
Air Date: 2018-12-03

32. Episode 32
Air Date: 2018-12-17

1. Kalmar Nyckel - the pursuit of North America's riches
Air Date: 2019-01-07

2. The placebo experiment
Air Date: 2019-01-14

3. With the Northern Lights in sight
Air Date: 2019-01-21

4. The drugs in Hitler's army
Air Date: 2019-01-28

5. Decoding the Weather Machine, Part 1
Air Date: 2019-02-04

6. Decoding the Weather Machine, Part 2
Air Date: 2019-02-11

7. Superpowers of bears
Air Date: 2019-02-18

8. Unknown sides of the T-rex
Air Date: 2019-02-25

9. The first british man
Air Date: 2019-03-04

10. The time of the forest fires
Air Date: 2019-03-11

11. Apollo 8 - first lap around the moon
Air Date: 2019-03-18

12. The primordial force of the lavine
Air Date: 2019-03-25

13. Deadly pills
Air Date: 2019-04-01

14. England's Pompeii
Air Date: 2019-04-08

15. Einstein's successors
Air Date: 2019-04-15

16. Full moon
Air Date: 2019-04-22

17. The image of the black hole
Air Date: 2019-04-29

18. Dangerous drivers
Air Date: 2019-05-06

19. Fire in the mountain
Air Date: 2019-05-13

20. The first moon landing
Air Date: 2019-05-27

21. Episode 21
Air Date: 2019-08-18

22. Episode 22
Air Date: 2019-08-25

23. Episode 23
Air Date: 2019-09-01

24. Episode 24
Air Date: 2019-09-08

25. Episode 25
Air Date: 2019-09-15

26. Episode 26
Air Date: 2019-09-22

27. Episode 27
Air Date: 2019-10-07

28. Episode 28
Air Date: 2019-10-13

29. Episode 29
Air Date: 2019-10-20
30. Episode 30
Air Date: 2019-10-27

31. Episode 31
Air Date: 2019-11-03
32. Episode 32
Air Date: 2019-11-10
33. Episode 33
Air Date: 2019-11-17
34. Episode 34
Air Date: 2019-11-24
35. Episode 35
Air Date: 2019-12-01
36. Episode 36
Air Date: 2019-12-08
1. Episode 1
Air Date: 2020-01-13
2. Episode 2
Air Date: 2020-01-20
3. Episode 3
Air Date: 2020-01-27
4. Episode 4
Air Date: 2020-02-03
5. Episode 5
Air Date: 2020-02-10

6. Episode 6
Air Date: 2020-02-17
7. Episode 7
Air Date: 2020-02-24
8. Episode 8
Air Date: 2020-03-02
9. Episode 9
Air Date: 2020-03-09

10. Episode 10
Air Date: 2020-03-16

11. Episode 11
Air Date: 2020-03-23

12. Episode 12
Air Date: 2020-03-30

13. Episode 13
Air Date: 2020-04-06
14. Episode 14
Air Date: 2020-04-13

15. Episode 15
Air Date: 2020-04-20
16. Episode 16
Air Date: 2020-04-27
17. Episode 17
Air Date: 2020-05-04
18. Episode 18
Air Date: 2020-05-11

19. Episode 19
Air Date: 2020-08-17
20. Episode 20
Air Date: 2020-08-24
21. Episode 21
Air Date: 2020-08-31

22. Episode 22
Air Date: 2020-09-07

23. Episode 23
Air Date: 2020-09-14

24. Episode 24
Air Date: 2020-08-21

25. Episode 25
Air Date: 2020-10-12

26. Episode 26
Air Date: 2020-10-19

27. Episode 27
Air Date: 2020-10-26

28. Episode 28
Air Date: 2020-11-02

29. Episode 29
Air Date: 2020-11-09

30. Episode 30
Air Date: 2020-11-16

31. Episode 31
Air Date: 2020-11-23

32. Episode 32
Air Date: 2020-11-29

33. Episode 33
Air Date: 2020-12-06

34. Episode 34
Air Date: 2020-12-13

1. Episode 1
Air Date: 2021-01-10

2. Episode 2
Air Date: 2021-01-17

3. Episode 3
Air Date: 2021-01-24

4. Episode 4
Air Date: 2021-01-31

5. Episode 5
Air Date: 2021-02-07

6. Episode 6
Air Date: 2021-02-14

7. Episode 7
Air Date: 2021-02-21

8. Episode 8
Air Date: 2021-02-28

9. Episode 9
Air Date: 2021-03-07

10. Episode 10
Air Date: 2021-03-14

11. Episode 11
Air Date: 2021-03-21

12. Episode 12
Air Date: 2021-03-28

13. Episode 13
Air Date: 2021-04-04

14. Episode 14
Air Date: 2021-04-11

15. Episode 15
Air Date: 2021-04-18

16. Episode 16
Air Date: 2021-04-25

17. Episode 17
Air Date: 2021-05-02

18. Episode 18
Air Date: 2021-05-09

19. Episode 19
Air Date: 2021-05-16

21. Episode 21
Air Date: 2021-06-13

31. Episode 31
Air Date: 2021-08-29

32. Episode 32
Air Date: 2021-09-05

33. Episode 33
Air Date: 2021-09-12

34. Episode 34
Air Date: 2021-10-10

35. Episode 35
Air Date: 2021-10-17

36. Episode 36
Air Date: 2021-10-24

37. Episode 37
Air Date: 2021-10-31

38. Episode 38
Air Date: 2021-11-07

39. Episode 39
Air Date: 2021-11-14

40. Episode 40
Air Date: 2021-11-21

41. Episode 41
Air Date: 2021-11-28

42. Episode 42
Air Date: 2021-12-05

43. Episode 43
Air Date: 2021-12-12

1. Episode 1
Air Date: 2022-01-09

2. Episode 2
Air Date: 2022-01-16

3. Episode 3
Air Date: 2022-01-23

4. Episode 4
Air Date: 2022-01-30

5. Episode 5
Air Date: 2022-02-06

6. Episode 6
Air Date: 2022-02-13

7. Episode 7
Air Date: 2022-02-20

8. Episode 8
Air Date: 2022-02-27

9. Episode 9
Air Date: 2022-03-06

10. Episode 10
Air Date: 2022-03-13

11. Episode 11
Air Date: 2022-03-20

12. Episode 12
Air Date: 2022-03-27

13. Episode 13
Air Date: 2022-04-03

14. Episode 14
Air Date: 2022-04-10

15. Episode 15
Air Date: 2022-04-17

16. Episode 16
Air Date: 2022-04-24

17. Episode 17
Air Date: 2022-05-01

18. Episode 18
Air Date: 2022-05-08

19. Episode 19
Air Date: 2022-05-08

20. Episode 20
Air Date: 2022-05-15

21. Episode 21
Air Date: 2022-08-21

22. Episode 22
Air Date: 2022-08-28

23. Episode 23
Air Date: 2022-09-04

24. Episode 24
Air Date: 2022-09-11

25. Episode 25
Air Date: 2022-09-18

26. Episode 26
Air Date: 2022-09-25

27. Episode 27
Air Date: 2022-10-02

28. Episode 28
Air Date: 2022-10-09

29. Episode 29
Air Date: 2022-10-16

30. Episode 30
Air Date: 2022-10-23

31. Episode 31
Air Date: 2022-10-30

32. Episode 32
Air Date: 2022-11-06

33. Episode 33
Air Date: 2022-11-13

34. Episode 34
Air Date: 2022-11-20

35. Episode 35
Air Date: 2022-12-04

36. Episode 36
Air Date: 2022-12-18

1. Episode 1
Air Date: 2023-01-08

2. Episode 2
Air Date: 2023-01-15

3. Episode 3
Air Date: 2023-01-22

4. Episode 4
Air Date: 2023-01-29

5. Episode 5
Air Date: 2023-02-05

6. Episode 6
Air Date: 2023-02-05

7. Episode 7
Air Date: 2023-02-12

8. Episode 8
Air Date: 2023-02-19

9. Episode 9
Air Date: 2023-02-26

10. Episode 10
Air Date: 2023-03-05

11. Episode 11
Air Date: 2023-03-12

12. Episode 12
Air Date: 2023-03-19

13. Episode 13
Air Date: 2023-03-26

14. The necessary zero
Air Date: 2023-04-02

15. Episode 15
Air Date: 2023-04-09

16. Episode 16
Air Date: 2023-04-16

17. Episode 17
Air Date: 2023-04-23

18. Episode 18
Air Date: 2023-04-30

19. Eye against the Universe
Air Date: 2023-05-07

20. Episode 20
Air Date: 2023-05-14

21. Episode 21
Air Date: 2023-06-04

22. Episode 22
Air Date: 2023-06-11

23. Episode 23
Air Date: 2023-08-27

24. Episode 24
Air Date: 2023-09-03

25. Episode 25
Air Date: 2023-09-10

26. Episode 26
Air Date: 2023-09-17

27. Episode 27
Air Date: 2023-09-24

28. Episode 28
Air Date: 2023-10-01

29. Estonia and the Myths
Air Date: 2023-10-08

30. Episode 30
Air Date: 2023-10-15

31. Episode 31
Air Date: 2023-10-22

32. Episode 32
Air Date: 2023-10-22

33. Episode 33
Air Date: 2023-11-05

34. Episode 34
Air Date: 2023-11-12

35. Episode 35
Air Date: 2023-11-19

36. Episode 36
Air Date: 2023-11-26

37. Nobel: Quantum dots, Attoseconds, and mRNA-vaccines
Air Date: 2023-12-03

38. Episode 38
Air Date: 2023-12-10

1. Episode 1
Air Date: 2024-01-07

2. Snow's superpowers
Air Date: 2024-01-14

3. Episode 3
Air Date: 2024-01-21

4. Episode 4
Air Date: 2024-01-28

5. The Science Behind the History of Sweden
Air Date: 2024-02-11

6. Episode 6
Air Date: 2024-02-18

7. How taste works 1 - We are salt and umami
Air Date: 2024-02-25

8. How taste works 2 - Sweet, sour, and bitter
Air Date: 2024-02-25

9. Episode 9
Air Date: 2024-03-10

10. Episode 10
Air Date: 2024-03-17

11. Episode 11
Air Date: 2024-03-24

12. Episode 12
Air Date: 2024-03-31

13. Episode 13
Air Date: 2024-04-07

14. Episode 14
Air Date: 2024-04-14

15. Episode 15
Air Date: 2024-04-21

16. Episode 16
Air Date: 2024-05-05

17. Episode 17
Air Date: 2024-05-12

18. Episode 18
Air Date: 2024-05-19

19. Episode 19
Air Date: 2024-05-23

20. Episode 20
Air Date: 2024-07-28

21. Episode 21
Air Date: 2024-08-25

22. Episode 22
Air Date: 2024-09-01

23. Episode 23
Air Date: 2024-09-08

24. Einstein's Worldview
Air Date: 2024-09-15

25. Episode 25
Air Date: 2024-09-22

26. Episode 26
Air Date: 2024-09-29

27. Episode 27
Air Date: 2024-10-06

28. Episode 28
Air Date: 2024-10-13

29. Episode 29
Air Date: 2024-10-20

30. Episode 30
Air Date: 2024-10-27

31. Episode 31
Air Date: 2024-11-03

32. Rome - technology in the 4th century
Air Date: 2024-11-10

33. Episode 33
Air Date: 2024-11-17

34. Episode 34
Air Date: 2024-11-24

35. Episode 35
Air Date: 2024-12-01

36. Notre-Dame reborn
Air Date: 2024-12-15

1. Episode 1
Air Date: 2025-01-12

2. Episode 2
Air Date: 2025-01-19

3. Episode 3
Air Date: 2025-01-26

4. Episode 4
Air Date: 2025-02-02

5. Episode 5
Air Date: 2025-02-09

6. Episode 6
Air Date: 2025-02-16

7. Episode 7
Air Date: 2025-02-23

8. Episode 8
Air Date: 2025-03-02

9. Episode 9
Air Date: 2025-03-09

10. When Sahara was green
Air Date: 2025-03-17

11. Episode 11
Air Date: 2025-03-23

12. The Hunt for Memory
Air Date: 2025-03-30

13. Inside the Super Storms
Air Date: 2025-04-13

14. Episode 14
Air Date: 2025-04-20

15. Episode 15
Air Date: 2025-04-27

16. Episode 16
Air Date: 2025-05-11

17. Battle of nuclear power 1 - The Big Turn
Air Date: 2025-05-18

18. Battle of nuclear power 2 - Bus to Chernobyl
Air Date: 2025-05-18

19. Battle of nuclear power 3 - Into the unknown
Air Date: 2025-05-18

20. Why bridges collapse
Air Date: 2025-06-01

21. Episode 21
Air Date: 2025-08-17

22. Episode 22
Air Date: 2025-08-24

23. Episode 23
Air Date: 2025-08-31

24. Episode 24
Air Date: 2025-09-07

25. Episode 25
Air Date: 2025-09-14

26. Episode 26
Air Date: 2025-09-21

27. Why Airplanes Crash
Air Date: 2025-09-28

28. Episode 28
Air Date: 2025-10-05

29. Episode 29
Air Date: 2025-11-02

30. Episode 30
Air Date: 2025-11-09

31. Episode 31
Air Date: 2025-11-16

32. Episode 32
Air Date: 2025-11-23

1. Episode 1
Air Date: 2026-01-11

2. Episode 2
Air Date: 2026-01-18

3. Episode 3
Air Date: 2026-01-25

4. Episode 4
Air Date: 2026-02-01

5. Episode 5
Air Date: 2026-02-22

6. Episode 6
Air Date: 2026-03-01

7. Episode 7
Air Date: 2026-03-08

8. Episode 8
Air Date: 2026-03-15

9. Episode 9
Air Date: 2026-03-23

10. Episode 10
Air Date: 2026-03-29

11. Episode 11
Air Date: 2026-04-05

12. Episode 12
Air Date: 2026-04-12

13. Episode 13
Air Date: 2026-04-19

14. Episode 14
Air Date: 2026-04-27

15. Episode 15
Air Date: 2026-05-04

16. Episode 16
Air Date: 2026-05-11
Select an episode to start watching
Rating
6.7/10
Release Date
1971-09-26
Episodes
970 (52 seasons)
Status
Returning Series
Cast
Production Companies
SVT